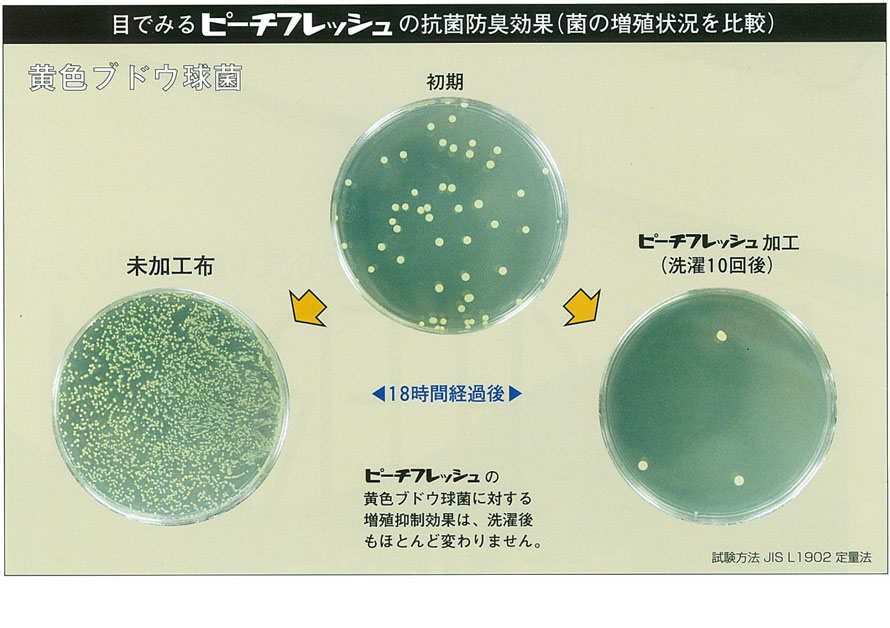
点と点の隙間を空気を通る

レディースサイズ表


カラー
明るく、清潔感のある全3色
レディース、メンズ、年齢も選ばないカラーバリエーション
-
- ホワイト

- ホワイトは、シンプルできれいなお色です。
-
- ミルク

- ミルクは、男女共に着ていただきやすいお色です。
-
- ラヴェンダー

- ラヴェンダーは、明るく上品なお色です。
- ※商品のお色につきましては、ご利用されるモニター、OSによっても実際の商品の色が多少異なって見える場合がございます。ご心配な方へ生地サンプルをお取り寄せ下さい
商品詳細
抗菌防臭ダブルガーゼレディースパジャマ上着単品・長袖/前開き/襟あり
PEACH FRESH DOUBLE GAUZE PAJAMA PRODUCT
| アイテム | レディース パジャマ 上着のみ 婦人 女性用 替えトップス |
|---|---|
| カテゴリー | ダブルガーゼ / 春 レディース / 襟あり |
| 仕様 | 長袖 前開き 開襟 |
| 素材 | 綿100% ダブルガーゼ 抗菌防臭加工 日清紡テキスタイルピーチフレッシュ加工生地使用 |
| 番手 / 打込本数 | 40番手 / 190本 |
| カラー | 6701 ホワイト / 6702 ミルク / 6703 ラヴェンダー |
| 寸法変化率 | タテ-3%、ヨコ-6% |
| 重量 / 厚み | 160g(Sサイズ) / 0.25mm |
| 生産国 | 日本製(織り:大阪 / 染め、加工:愛知 / 縫製:京都 岩本繊維) |
| サイズ | XS~12L (レディース) 【モデル:身長158cm Sサイズ着用】 |
X CLOSE
つくるパジャマのセミオーダーメイド
丈、仕様、サイズ、色まで自由自在
つくるパジャマで使用する生地は、ほぼ全て織り、染めも日本で行った国産生地で、京都の自社工場で縫製しています。
在庫はもたず、ご注文頂いてから1点1点職人がお作りするので、サイズはもちろん、細かな仕様まで自由自在にカスタマイズできます。今お持ちの布団にぴったりのあなた好みのカバーをお作り致します。
自分だけのオリジナルパジャマを簡単カスタマイズ
パジャマオプションサービス
セミオーダーメニュー
- - 丈をかえられます -
- あなたの体形、お好みにあわせて 長くする? 短くする?
-
01. 袖丈をかえる

1cm単位で丈をかえられます(未選択の場合はサイズ表どおり)
-
02. 着丈をかえる

1cm単位で丈をかえられます(未選択の場合はサイズ表どおり)
- - ゴムをいれられます -
- 洗顔や家事に便利♪
-
03. 袖ゴムをいれる

約1.5cm幅の平ゴムが入ります
- - ポケットの位置の変更、追加ができます -
- 利き手に合わせて場所を変更!
-
04. ポケット位置の変更・追加

本来の貼り付けポケットの位置を変更したり、さらにポケットを追加できます
まずは基本のサイズを選ぶ
一番大きいところを基準にしてください
※お腹周りがバストより出ている場合は、お腹周りを基準にサイズをお選びください。裾周りのサイズがお腹周りの実寸+約20cmになっているかを目安にしてください。
option.01
上着の袖丈が変えられます
袖口から最大10cmまで1cm単位で短く、長くできます


お手持ちのパジャマの袖丈があわない方に
お手持ちのパジャマの裄丈を計測する

身幅に合わせると袖丈が長い、短いなど、袖の長さにいつもお困りではありませんか。お手持ちのパジャマから、サイズ調整する場合は、首の真後ろ(うしろ襟ぐり付け根の中心)から袖の先までの長さを計測してください。(=裄丈 このパジャマは75cm)
※お手持ちのパジャマの身幅、肩幅がつくるパジャマとほぼ同じサイズ感なら、袖丈のみ比較してください。
サイズ表とくらべて、調整するサイズを計算する

いろんなデザインのパジャマがあるため、各メーカーや商品によって、袖の始まる位置などが若干違う場合があります。そのため裄丈で比較していただくのが安心です。
- (肩幅÷2)+袖丈=裄丈
- ① バストが90cmの場合、基本サイズはバスト対応寸法からMサイズを選ぶ
② 肩幅(49÷2)+(袖丈)57=(裄丈)81.5cm・・・つくるパジャマのMサイズの裄丈
③ お手持ちのパジャマから希望の裄丈は75cmのため81.5-75=-6.5cm短くする
→袖丈6cm短くするのオプションを選ぶ(短くしすぎると、お直しもできません。迷ったときは長めで御確認を)
option.02
上着の着丈が変えられます
すそから最大10cmまで1cm単位で短く、長くできます


※着丈はうしろ襟ぐり付け根の中心から裾までです。お歳を召すと、背中がまがってきますので、着丈は若干の余裕があっても心配ないかと存じます。
option.03
上着のそで口にゴムを入れられます
腕まくりするのに便利なくらいのゴムあがりにします


※プレゼントの場合などで、袖丈がわからない時は、袖ゴムオプションをつけておけば安心です
※睡眠時に使用するので、ゆったり希望の方は、通信欄に「ゴム上がり、ワンサイズ大き目希望」とご記載ください。
もちろん小さく縮めることもできます。
option.04
上着ポケットの位置が変更、追加できます
ポケットのタイプも選べます


貼り付けポケット(13×16cm)の位置がかえられます。また追加も可能です。
※貼り付けポケットの位置はデザインによってかわります。
オプションサービスランキング
-
1

袖詰めサービス
身長が高くない日本人に本当によくあるサイズ感のお悩みです。当店で一番多くご利用いただいております。
-
2

ポケット追加
コロナ禍でルームウェア感覚でお使いになられる方が増えています。ズボンのスラッシュポケット追加サービス。
-
3

袖ゴムサービス
手首が冷えるのが苦手な方や朝、パジャマのまま家事や洗顔などをされる方に。また少し大きめサイズを着たい方にも手首がとめられ便利です。
X CLOSE
お洗濯・耐久性について
じゃぶじゃぶ洗っても大丈夫
MACHINE WASHABLE
お洗濯方法

![]()
- 洗濯機で丸洗い可能(40度以下弱水流)
- 直射日光のあたらない吊り干しにして下さい。
- 乾燥機、漂白剤のご使用はお避け下さい。
- 汗や雨、お洗濯時に濡れたままにしておきますと色移りすることがあります。
くらべてみました(10回洗濯後)
お客様からのお問い合わせが多い洗濯後の変化です。色褪せ、表面変化、縮みぐあいです。
カラー:ズボン ラヴェンダー
- 色褪せ
-

【新品】
洗濯前はすっきりと、色もきれいです
-

【10回洗濯後】
10回洗濯後も、シワはできますが、色褪せなど表面変化はほぼ見られませんでした
- 表面変化
- (毛玉、毛羽立ちぐあい)
-

【新品】
新品時はさらっとやわらかい感触です
-

【10回洗濯後】
少し毛羽立ちはありますが、毛玉は見当たりません
- 縮み
- ズボンを10回洗濯後(吊り影干しにて約24時間:冬場)
-

【新品がグレー、生成が10回洗濯後】
新品と同じように洗濯後、アイロンをかけると1%ほど縮み、表記の収縮率におさまりました。(収縮具合は洗濯環境によってかわります)
生地一覧
春秋のおすすめ生地一覧
List of recommended spring and autumn fabrics
和晒ダブルガーゼ以外にも、春秋にぴったりな生地をたくさんとりそろえております。生地の素材やお色などをかえて、いろいろ揃えたくなる生地です。
-
伝統のある和晒製法で時間をかけて仕上げた、年中使えるダブルガーゼ。2枚の生地を点で結合しているので、熱や汗を放出しやすく通気性抜群!洗えば洗うほどふわふわに、肌に馴染んできます。
-
オーガニックコットンを使用し、お肌にも環境にもやさしいダブルガーゼ。高級なコーマ糸を使用しているので、しなやかでやわらかい肌触りに仕上がっています。
-
従来のダブルガーゼより約30%も軽量化!貴重な極細の80番手糸を使用することで、ほどよい光沢感のある、するんとなめらかなガーゼに。コンパクト糸を使用しているので、毛羽も少なくなっています。
-
抗菌防臭効果のある、ピーチフレッシュ加工のダブルガーゼ。通気性や吸放湿性にも優れ、いつでもさらっと清潔にお過ごしいただけます。
-
高級感のあるペイズリー柄のダブルガーゼ。ホルマリン不使用染料なので、デリケートなお肌の方にも安心してお使いいただけます。
-
上品なローズ柄のダブルガーゼは、華やかでお部屋でも気分が上がります。ほどよい保温性と、ガーゼのふんわりやさしい肌触りが特徴です。
-
かわいらしい小花が散りばめられたダブルガーゼ。電力と排水にかかる負荷が少ない、地球環境に優しいインクジェットプリントを採用しています。
X CLOSE
注意事項
- 本商品はご注文を受けてから1枚ずつ隣接する自社工場でお作りするオーダーメイド商品です。(受注生産品)
- 「製造開始」してからのお客様都合によるキャンセル・返品交換はお受け致しかねます。サイズ・色をお間違えないようご確認下さい。
- ご注文直後で製造開始前のキャンセル・変更はお電話またはメールにてお受け致します。
- 商品のお色につきましては、ご利用されるモニター、OSによっても実際の商品の色が多少こと合ってみえる場合がございます。ご心配な方は生地サンプルをお取り寄せください(無料)
- 仕様変更は事前の告知なく変更する場合がございます。予めご了承下さい。
- 生地ロットによっては色ブレや風合いが異なる場合がございます。
X CLOSE
-
この商品の
サンプル生地をとりよせる - オーダーメイド
対象商品 - 2年保証対象商品

洗うたびにふんわり柔らかい
抗菌防臭加工のピーチフレッシュダブルガーゼ
スモールカラーレディースパジャマ上着単品
清潔でふんわり柔らかい着心地
概要
- 敏感肌の方も安心!綿100%のガーゼ生地
- 洗えば洗うほどふわふわに!
- 安心の日清紡テキスタイルピーチフレッシュ抗菌防臭加工生地使用
- 優れた通気性、吸水性、吸湿性


素材について
敏感肌の方も安心 綿100%ダブルガーゼ
SEK取得の日清紡ピーチフレッシュ加工で清潔
綿100%ダブルガーゼ襟ありパジャマ。汗や皮脂で汚れやすいパジャマも日清紡テキスタイルピーチフレッシュ抗菌防臭加工のダブルガーゼ生地を使用で清潔に

- - Point.01 -
- 洗えば洗うほど ふわふわに
メレンゲのように柔らかい綿100%ダブルガーゼは、使い込むほどに、さらに自分の肌になじむような柔らかさになります。まさに、ガーゼが育っていくように、日々ふんわりさと柔らかさが増していくのを感じていただけます。

- - Point.02 -
- 敏感肌にやさしい綿100%ダブルガーゼ生地
赤ちゃんのおくるみなどにもよく使われるほど、ガーゼ素材はお肌に優しく、デリケートな肌の方にも安心してお使い頂けるおすすめ素材です。ざっくり編んだ綿100%ダブルガーゼ生地を使用しています。40番手という太番手の糸をざっくり粗く織りあげ通気性も抜群です。

- - Point.03 -
- 安心の日清紡テキスタイルピーチフレッシュ抗菌防臭加工生地使用
約20%の人の皮膚に存在するといわれる黄色ブドウ球菌。肌が直接ふれるパジャマだからこそ汗臭の原因となる黄色ブドウ球菌の増殖をおさえ快適に

- - Point.04 -
- 優れた通気性、吸水性、吸湿性
2枚の綿100%ガーゼ生地をところどころ点で、結合して織られています。点結することで空気の通り道が多くでき、熱や汗を放出、通気性抜群です。また、2枚のガーゼ間に空気層ができ、サラっと爽やかに年中使えるダブルガーゼ襟ありパジャマです。

商品のデザイン
寝返りも楽々。部屋着ぽいすっきりデザイン
見た目は普段着ぽく、着心地はリラックスウェアのように
まるでシャツのような細目ステッチ、小さ目ボタン、スワローテール

襟ありのまるでシャツのようなデザインのパジャマ。突然の来客や、ちょっとそこまでの外出にも使えて便利。滑らかな肌ざわりは一日中着ていたくなるほど。パジャマはもちろん、ルームウェアにもぴったりです。抗菌防臭加工のピーチフレッシュダブルガーゼで快適にお過ごし頂けます。
-

ちらりと覗くおしゃれなテープのワンポイント(全色同色)
-

お尻が少し隠れる後ろすそ丈。シャツのスワローテールを採用
-

スマホも入るポケットつき

長袖 前開き

1晩に平均20~30回の寝返りをするといわれています。 身体の一部に負担をかけない為にも、血行不良を防ぐ為にも必要です。締め付け感がなく、体を動かしやすい無理のないゆったりしたデザインです。
お腹にやさしいソフトゴム使用

ゴム取替口からゴムをひっぱりしばるなどし調節、交換ができます。
就寝中は締め付け感が少なくお腹にあたる部分もやさしい感触のものがおすすめです。当店で使用しているBBワッフル®ゴムは、ずれにくいのにきつすぎない、パジャマに最適なお腹にやさしいソフトゴムです。
![]()
- ゴムが折れたり、ひっくり返りにくい
- 締め付け感がソフト
- 肌触りが良い
- 洗濯しても効果が持続

安心の日本製
純国産、オリジナル商品
MADE IN JAPAN

1枚1枚、職人が京都の自社工場で縫製
滋賀と京都に自社工場をもつ、創業70年岩本繊維。大手百貨店やインテリアショップ、寝具店へのパジャマの卸し、ホテル等の館内着製造は年間10,000枚以上の多数販売実績がございます。原材料を輸入、染、織、加工縫製をすべて日本国内で行っているパジャマ専門店です。

- 素材の企画、商品開発、製造、出荷まで一貫して行っています
- つくるパジャマで使用する生地はほぼ全て織り、染めも日本で行った国産生地で、全て京都の自社工場で縫製しています。生地の開発、お客さまのご要望にきめこまかく対応し製造、出荷、アフターサービスまで一貫で行い責任をもつことで、お届けする商品には自信をもっております。自分たちの目の届くところで商品を作り、品質管理をし、改善を続けて参ります。
海外製と違う、濁りのない発色と繊細な加工

つくるパジャマでは、快眠に最適なコットン、リネン、シルクなどの天然素材のみを厳選し、さらに肌触りのよい生地にこだわっています。生地はほぼ全てオリジナルで、織りから、染め、仕上げ加工まで日本国内のものがほとんどです。直接、現地工場に足を運び、各分野のエキスパートに「こんなことできないか」と相談しながら生地を企画することもしばしば。とことん心地よい生地を追求しています。
類似商品
|
商品名 サテンストライプレディースパジャマ |
商品名 やわらか天竺ニットレディースパジャマ |
商品名 スーピマ超長綿レディースパジャマ |
商品名 ペイズリーダブルガーゼレディースパジャマ |
商品名 40オーガニックコットンダブルガーゼレディースパジャマ |
商品名 花柄ダブルガーゼ-Royal Rose-レディースパジャマ |
商品名 ボーダーニットレディースパジャマ |
商品名 両面パイルニットレディースパジャマ |
商品名 川俣シルクサテンレディースパジャマ |
|
| カテゴリ | サテンストライプ | 天竺ニット | スーピマ超長綿サテン | ペイズリーダブルガーゼ | 40オーガニックコットンダブルガーゼ | 花柄ダブルガーゼ-Royal Rose- | ボーダーニット | 両面パイルニット | 川俣シルクサテン |
| 商品番号 | ttl07-tbl01_8900 | ttl07-tbl01_8100 | ttl07-tbl01_9300 | ttl07-tbl01_dg504 | ttl07-tbl01_7400 | ttl07-tbl01_fl001 | ttl07-tbl01_409 | ttl07-tbl01_494 | ttl07-tbl01_41000 |
| 価格 | \9,240- | \9,350- | \9,900- | \9,900- | \9,900- | \9,900- | \10,780- | \14,300- | \41,800- |
| 素材 | 綿100% | 綿100% | 綿100% 超長綿 |
綿100% | 綿100% | 綿100% | 綿100% | 綿100% セミコーマ糸 |
絹100% |
| 番手/打込本数 | 60番手 / 260本 | 40番手 / 28ゲージ | 80番手 / 280本 | 40番手 / 190本 | 40番手 / 195本 | 40番手 / 195本 | 20番手 双糸 / 12ゲージ | 40番手 / 28ゲージ | タテ42デニール ヨコ84デニール / タテ300 ヨコ112 |
| 織り | サテン織り | 天竺編み ニット |
サテン織り | 平織り ガーゼ |
平織り ガーゼ |
平織り ガーゼ |
天竺編み ニット |
丸編み ニット |
サテン織り |
| 加工 (その他) |
|||||||||
| シーズン | 春秋 | 春秋 | 春秋 | 春秋 | 春秋 | 春秋 | 春秋 | 春秋 | 春秋 |
| 保温性 |
|
|
|
|
|
|
|
|
|
| 厚み | 0.17mm | 0.42mm | 0.21mm | 0.38mm | 0.40mm | 0.43mm | 0.71mm | 1.00mm | 0.19mm |
| 重量 (レディースS) |
241g | 290g | 209g | 278g | 297g | 204g(M) | 425g | 486g | 198g(M) |
| 透け感 |
|
|
|
|
|
|
|
|
|
| 伸縮性 |
|
|
|
|
|
|
|
|
|
| 寸法変化率 | タテ-3%、ヨコ-3% | タテ-5%、ヨコ-10% | タテ-3%、ヨコ-3% | タテ-3%、ヨコ-3% | タテ-3%、ヨコ-3% | タテ-3%、ヨコ-3% | タテ-8%、ヨコ-3% | タテ-5%、ヨコ-5% | タテ-4%、ヨコ-3% |
おすすめキーワードから探す
売れ筋ランキング
-Item Ranking-
- レディース
- メンズ
- ガールズ
- ボーイズ


















